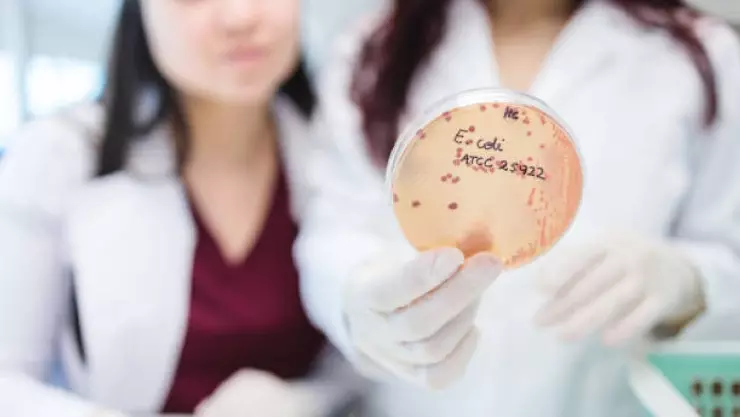
E. coli

El E. coli (Escherichia coli) es una bacteria que vive normalmente en el intestino de personas y animales sin causar daño. Sin embargo, ciertas cepas patógenas producen toxinas que provocan infecciones graves.
Se puede transmitir por alimentos o agua contaminados, contacto con animales, o por tener una higiene deficiente. Dicha bacteria provoca mayor riesgo en niños y adultos mayores.
¿Cómo se contagia el E. coli?
E. coli forma parte de la microbiota intestinal, pero las cepas son las que generan la enfermedad. La vía principal de contagio es fecal u oral, y los casos más comunes son:
- Carne molida mal cocida.
- Verduras regadas con agua contaminada.
- Leche o jugos no pasteurizados.
- Albercas o contacto de persona a persona.
Síntomas por infección de E. coli
Los síntomas suelen aparecer entre 1 y 10 días tras el contagio:
- Diarrea acuosa o sanguinolenta (colitis hemorrágica).
- Dolor abdominal intenso tipo cólico.
- Vómitos y fiebre baja.
En casos muy graves, puede provocar insuficiencia renal aguda, anemia hemolítica y trombocitopenia, por lo que la hospitalización inmediata será clave en este nivel de infección.
¿Cuál es el tratamiento a seguir contra el E. coli?
No se deben de usar antibióticos rutinarios ya que pueden aumentar la liberación de toxinas y empeorar la enfermedad. Asimismo, se recomienda:
- Rehidratación oral o intravenosa.
- Control de electrolitos.
- Diálisis en caso de fallo renal.
¿Cuándo llegaría el 3iAtlas a la tierra?